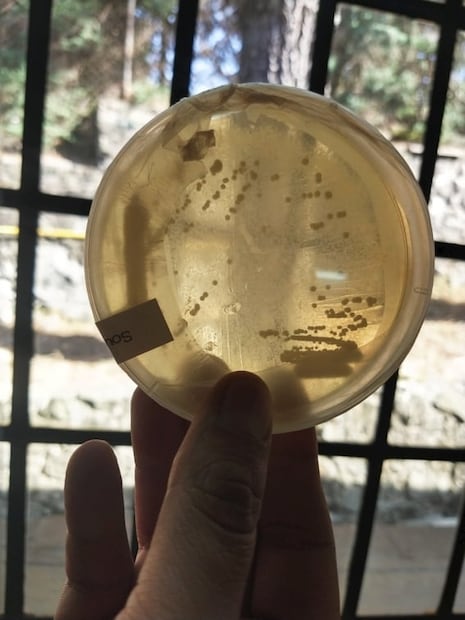
Conoce Monstruo de Agua, una cervecería artesanal comprometida con el medio ambiente

[Publicidad]
Al sur de la Ciudad de México, en Topilejo, encontramos el Jardín del Ajolote. Desde ahí, lo maestros cerveceros Matías Vera-Cruz y Pablo Serrano así como el microbiólogo Luis Manuel Serrano cocinan cerveza sustentable.
- El ajolote es representativo del país, es autóctono y símbolo de la regeneración y la sustentabilidad
El agua que utilizan es de lluvia, la captan desde el techo de la mini fábrica la cual filtran y almacenan. Otra de las prácticas que han distinguido a esta cervecería artesanal, es el uso de hierbas y flores (llamados adjuntos) como la lavanda, el mastuerzo, cempasúchil nativo de pétalos muy pequeños y con mucho aroma, además de hongos como ya te hemos platicado .

- Semilla de cilantro, mieles nativas, higo, mango, tuna, jamaica, cáscara de naranja, mandarina y jengibre son algunos ingredientes que han estado presentes en sus ediciones especiales.

Otros de los elementos que incluyen en su grupo de cereales son el amaranto, un cereal cultivado en Tulyehualco, así como el maíz, dos elementos que aportan texturas y sabores dulces a la cerveza.
Leer más: Cómo preparar cerveza en casa
Por su parte, Pablo Serrano, le da un plus que ninguna otra cervecera artesanal tiene en México, la generación de la levadura, la cual obtiene del mismo lugar en donde se obtiene, principalmente de un árbol que habita en la propiedad, inocula la levadura y la deja crecer.
Su inquietud ha ido más allá con la creación de bitters, sodas probióticas llamadas Chinampa, además de sidras. Nosotros ya probamos la de ciruela y debemos decir que es dulce y de una acidez equilibrada.

El año pasado ganaron la mención a la Mejor Marca Sostenible del Año en los Goula Awards, así como la obtención de medallas en Copa Cerveza México con un oro en la categoría de Cervezas Experimentales con su etiqueta Blanca de Maguey, así como plata en Slow Beer México.
Leer más: La única cerveza hecha con hongos oaxaqueños
Síguelos en sus redes y en Cerveza México, un evento que tendremos la próxima semana
Noticias según tus intereses
[Publicidad]











